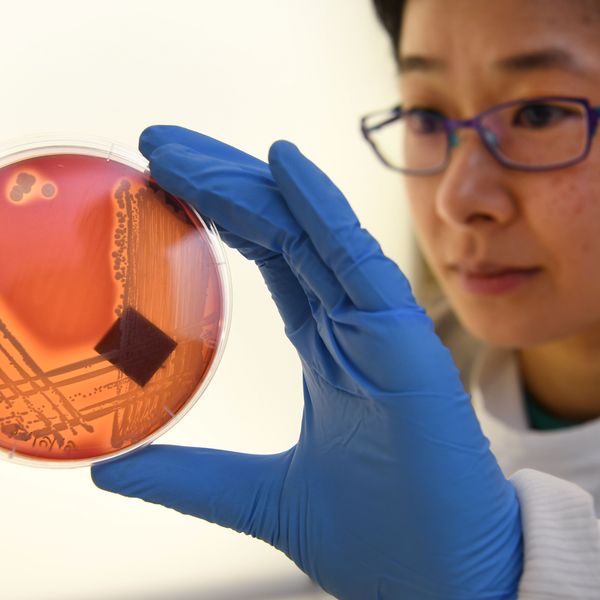
AUSTRALIA-HEALTH-HOSPITAL-DISEASE-SUPERBUG

Farmworker Adrian Gonzalez irrigates a field of newly planted alfalfa on December 29, 2022 in Calipatria, California.
Low-Paid Immigrant Farmworkers Most at Risk From Toxic Weedkiller US Refuses to Ban
Farmworkers "should not be subjected to additional health risks due to the negligent actions of pesticide manufacturers, farm owners, and state regulatory agencies," said one analyst.
Concerns about the safety of paraquat, a highly toxic herbicide, pushed the U.S. Environmental Protection Agency in 2021 to ban its use on golf courses—but the weedkiller is still permitted for agricultural use, and a new first-of-its-kind analysis shows how the EPA's continued approval of the substance has put low-income Latino communities at disproportionate risk for health impacts.
The Environmental Working Group (EWG) found in a study released Wednesday that 5.3 million pounds of paraquat were sprayed over a five-year period in California, the only state with readily available figures on the herbicide.
Most of the weedkiller's use was concentrated in central counties where farms produce almonds, walnuts, alfalfa, and other crops—and where Latino people make up about 75% of the population and nearly the entire farm labor force.
Ninety-six percent of farmworkers in the state are Latino, and 90% of people in the agricultural workforce were born outside of the U.S., making immigrants who often work for low wages among the people who are most affected by continued use of paraquat on farms.
The ingestion of a single teaspoon of paraquat is considered deadly, which has led 60 countries to ban the chemical while the EPA released an analysis in January concluding that its health risks were outweighed by the economic benefits of using paraquat.
The weedkiller has been linked to non-Hodgkin lymphoma, respiratory damage, kidney disease, and childhood leukemia. Al Rabine, an analyst for EWG who authored the report, said the EPA has also ignored a "mountain of evidence" that paraquat causes Parkinson's disease.
An epidemiological study of central California found that people living within a third of a mile of where paraquat is sprayed are twice as likely to develop Parkinson's.
"Paraquat is not only a threat to our environment but also a direct danger to the health and well-being of these communities, particularly Latino populations, who make up the majority of the population," said Rabine. "The findings of our analysis underscore the urgent need for action by the state to protect these communities from the harmful effects of exposure to this toxic weedkiller."
Between 2017-21, EWG found, about 80% of the paraquat used on California crops was sprayed within Latino-majority census tracts. The group identified Kern County and the towns of Shafter and Wasco as "hot spots" for paraquat use.
"These three communities combined have over 80% Latino residents who witnessed almost 180,000 pounds of paraquat spraying during that time period," the group said.
In Kern County, which has a poverty rate of nearly 30%, EWG found that 1.2 million pounds of the herbicide were sprayed over roughly 1,200 square miles of farmland—threatening not only laborers who completed the work but also farmworkers who live in the surrounding communities, as paraquat can remain in soil and travel through the air—as well as coming home with workers on their clothing and potentially exposing their families.
EWG identified five "fatal flaws" in the analysis the EPA has used to defend its continued approval of paraquat for farming, including:
- Ignoring new evidence about the potential health impacts of paraquat that has come out of legal action against its manufacturer, the Switzerland-based and Chinese-owned Syngenta;
- Ignoring the fact that paraquat use is largely concentrated in specific communities inhabited largely by low-income Latino farmworkers;
- Excluding from its safety analysis paraquat applications that can drift through the aid, especially on windy days;
- Failing to consider the health and environmental costs to farm owners, workers, and people who live near farmland; and
- Dismissing a growing body of research linking paraquat to Parkinson's, including 90 articles of evidence and "cutting edge studies" submitted by the Michael J. Fox Foundation for Parkinson's Research.
EWG called on the EPA to follow the lead of dozens of countries that have banned paraquat—but warned that states must not wait for the federal government to take action.
"Federal pesticide law sets a floor, not a ceiling—states can choose to restrict a chemical, even without an EPA ban," wrote EWG government affairs manager Geoff Horsfield and toxicologist Alexis Temkin. "To protect their residents and public health, state and local governments should exercise their power to ban paraquat."
Immigrant communities across central California, Horsfield said, "should not be subjected to additional health risks due to the negligent actions of pesticide manufacturers, farm owners, and state regulatory agencies."
An Urgent Message From Our Co-Founder
Dear Common Dreams reader, The U.S. is on a fast track to authoritarianism like nothing I've ever seen. Meanwhile, corporate news outlets are utterly capitulating to Trump, twisting their coverage to avoid drawing his ire while lining up to stuff cash in his pockets. That's why I believe that Common Dreams is doing the best and most consequential reporting that we've ever done. Our small but mighty team is a progressive reporting powerhouse, covering the news every day that the corporate media never will. Our mission has always been simple: To inform. To inspire. And to ignite change for the common good. Now here's the key piece that I want all our readers to understand: None of this would be possible without your financial support. That's not just some fundraising cliche. It's the absolute and literal truth. We don't accept corporate advertising and never will. We don't have a paywall because we don't think people should be blocked from critical news based on their ability to pay. Everything we do is funded by the donations of readers like you. Will you donate now to help power the nonprofit, independent reporting of Common Dreams? Thank you for being a vital member of our community. Together, we can keep independent journalism alive when it’s needed most. - Craig Brown, Co-founder |
Concerns about the safety of paraquat, a highly toxic herbicide, pushed the U.S. Environmental Protection Agency in 2021 to ban its use on golf courses—but the weedkiller is still permitted for agricultural use, and a new first-of-its-kind analysis shows how the EPA's continued approval of the substance has put low-income Latino communities at disproportionate risk for health impacts.
The Environmental Working Group (EWG) found in a study released Wednesday that 5.3 million pounds of paraquat were sprayed over a five-year period in California, the only state with readily available figures on the herbicide.
Most of the weedkiller's use was concentrated in central counties where farms produce almonds, walnuts, alfalfa, and other crops—and where Latino people make up about 75% of the population and nearly the entire farm labor force.
Ninety-six percent of farmworkers in the state are Latino, and 90% of people in the agricultural workforce were born outside of the U.S., making immigrants who often work for low wages among the people who are most affected by continued use of paraquat on farms.
The ingestion of a single teaspoon of paraquat is considered deadly, which has led 60 countries to ban the chemical while the EPA released an analysis in January concluding that its health risks were outweighed by the economic benefits of using paraquat.
The weedkiller has been linked to non-Hodgkin lymphoma, respiratory damage, kidney disease, and childhood leukemia. Al Rabine, an analyst for EWG who authored the report, said the EPA has also ignored a "mountain of evidence" that paraquat causes Parkinson's disease.
An epidemiological study of central California found that people living within a third of a mile of where paraquat is sprayed are twice as likely to develop Parkinson's.
"Paraquat is not only a threat to our environment but also a direct danger to the health and well-being of these communities, particularly Latino populations, who make up the majority of the population," said Rabine. "The findings of our analysis underscore the urgent need for action by the state to protect these communities from the harmful effects of exposure to this toxic weedkiller."
Between 2017-21, EWG found, about 80% of the paraquat used on California crops was sprayed within Latino-majority census tracts. The group identified Kern County and the towns of Shafter and Wasco as "hot spots" for paraquat use.
"These three communities combined have over 80% Latino residents who witnessed almost 180,000 pounds of paraquat spraying during that time period," the group said.
In Kern County, which has a poverty rate of nearly 30%, EWG found that 1.2 million pounds of the herbicide were sprayed over roughly 1,200 square miles of farmland—threatening not only laborers who completed the work but also farmworkers who live in the surrounding communities, as paraquat can remain in soil and travel through the air—as well as coming home with workers on their clothing and potentially exposing their families.
EWG identified five "fatal flaws" in the analysis the EPA has used to defend its continued approval of paraquat for farming, including:
- Ignoring new evidence about the potential health impacts of paraquat that has come out of legal action against its manufacturer, the Switzerland-based and Chinese-owned Syngenta;
- Ignoring the fact that paraquat use is largely concentrated in specific communities inhabited largely by low-income Latino farmworkers;
- Excluding from its safety analysis paraquat applications that can drift through the aid, especially on windy days;
- Failing to consider the health and environmental costs to farm owners, workers, and people who live near farmland; and
- Dismissing a growing body of research linking paraquat to Parkinson's, including 90 articles of evidence and "cutting edge studies" submitted by the Michael J. Fox Foundation for Parkinson's Research.
EWG called on the EPA to follow the lead of dozens of countries that have banned paraquat—but warned that states must not wait for the federal government to take action.
"Federal pesticide law sets a floor, not a ceiling—states can choose to restrict a chemical, even without an EPA ban," wrote EWG government affairs manager Geoff Horsfield and toxicologist Alexis Temkin. "To protect their residents and public health, state and local governments should exercise their power to ban paraquat."
Immigrant communities across central California, Horsfield said, "should not be subjected to additional health risks due to the negligent actions of pesticide manufacturers, farm owners, and state regulatory agencies."
- Federal Court Halts Spraying of Monsanto’s Dicamba Pesticide Across Millions of Acres of Cotton, Soybeans ›
- Renewed Calls to Ban Glyphosate After Toxic Herbicide Found in 80% of US Urine Samples ›
- Trump EPA Denounced for 'Disgusting' Decision on Atrazine, Herbicide Tied to Birth Defects ›
Concerns about the safety of paraquat, a highly toxic herbicide, pushed the U.S. Environmental Protection Agency in 2021 to ban its use on golf courses—but the weedkiller is still permitted for agricultural use, and a new first-of-its-kind analysis shows how the EPA's continued approval of the substance has put low-income Latino communities at disproportionate risk for health impacts.
The Environmental Working Group (EWG) found in a study released Wednesday that 5.3 million pounds of paraquat were sprayed over a five-year period in California, the only state with readily available figures on the herbicide.
Most of the weedkiller's use was concentrated in central counties where farms produce almonds, walnuts, alfalfa, and other crops—and where Latino people make up about 75% of the population and nearly the entire farm labor force.
Ninety-six percent of farmworkers in the state are Latino, and 90% of people in the agricultural workforce were born outside of the U.S., making immigrants who often work for low wages among the people who are most affected by continued use of paraquat on farms.
The ingestion of a single teaspoon of paraquat is considered deadly, which has led 60 countries to ban the chemical while the EPA released an analysis in January concluding that its health risks were outweighed by the economic benefits of using paraquat.
The weedkiller has been linked to non-Hodgkin lymphoma, respiratory damage, kidney disease, and childhood leukemia. Al Rabine, an analyst for EWG who authored the report, said the EPA has also ignored a "mountain of evidence" that paraquat causes Parkinson's disease.
An epidemiological study of central California found that people living within a third of a mile of where paraquat is sprayed are twice as likely to develop Parkinson's.
"Paraquat is not only a threat to our environment but also a direct danger to the health and well-being of these communities, particularly Latino populations, who make up the majority of the population," said Rabine. "The findings of our analysis underscore the urgent need for action by the state to protect these communities from the harmful effects of exposure to this toxic weedkiller."
Between 2017-21, EWG found, about 80% of the paraquat used on California crops was sprayed within Latino-majority census tracts. The group identified Kern County and the towns of Shafter and Wasco as "hot spots" for paraquat use.
"These three communities combined have over 80% Latino residents who witnessed almost 180,000 pounds of paraquat spraying during that time period," the group said.
In Kern County, which has a poverty rate of nearly 30%, EWG found that 1.2 million pounds of the herbicide were sprayed over roughly 1,200 square miles of farmland—threatening not only laborers who completed the work but also farmworkers who live in the surrounding communities, as paraquat can remain in soil and travel through the air—as well as coming home with workers on their clothing and potentially exposing their families.
EWG identified five "fatal flaws" in the analysis the EPA has used to defend its continued approval of paraquat for farming, including:
- Ignoring new evidence about the potential health impacts of paraquat that has come out of legal action against its manufacturer, the Switzerland-based and Chinese-owned Syngenta;
- Ignoring the fact that paraquat use is largely concentrated in specific communities inhabited largely by low-income Latino farmworkers;
- Excluding from its safety analysis paraquat applications that can drift through the aid, especially on windy days;
- Failing to consider the health and environmental costs to farm owners, workers, and people who live near farmland; and
- Dismissing a growing body of research linking paraquat to Parkinson's, including 90 articles of evidence and "cutting edge studies" submitted by the Michael J. Fox Foundation for Parkinson's Research.
EWG called on the EPA to follow the lead of dozens of countries that have banned paraquat—but warned that states must not wait for the federal government to take action.
"Federal pesticide law sets a floor, not a ceiling—states can choose to restrict a chemical, even without an EPA ban," wrote EWG government affairs manager Geoff Horsfield and toxicologist Alexis Temkin. "To protect their residents and public health, state and local governments should exercise their power to ban paraquat."
Immigrant communities across central California, Horsfield said, "should not be subjected to additional health risks due to the negligent actions of pesticide manufacturers, farm owners, and state regulatory agencies."
- Federal Court Halts Spraying of Monsanto’s Dicamba Pesticide Across Millions of Acres of Cotton, Soybeans ›
- Renewed Calls to Ban Glyphosate After Toxic Herbicide Found in 80% of US Urine Samples ›
- Trump EPA Denounced for 'Disgusting' Decision on Atrazine, Herbicide Tied to Birth Defects ›